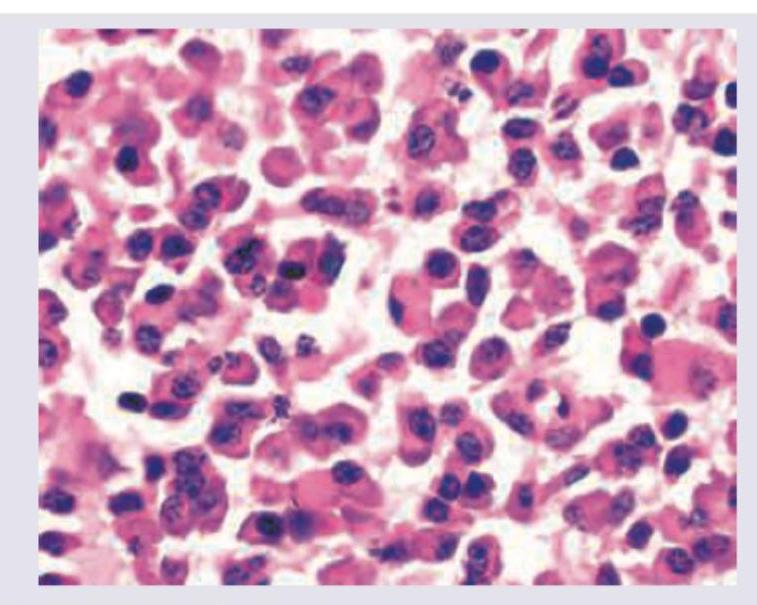
Image for question 1318

Which of the following is a change seen in irreversible cell injury?
Which of the following types of cell death involves activation of caspase enzymes?
Identify the tissue shown in the histopathological image:

All are true about the cartilage shown in the figure except: (Recent NEET Pattern 2016-17)

A 6-month-old child presents with loss of vision and regression of milestones. On examination hepatosplenomegaly and lymphadenopathy is seen. The bone marrow aspiration shows abnormal macrophage shown below. It stains positive for fat and negative for iron. Identify the cell.

A karyotype is shown in the image. What is the most likely diagnosis?

Agarose gel electrophoresis from DNA of a population of cells as seen under ultraviolet light is shown below. What is the correct explanation for the finding seen in the band labeled as "C"?

Identify the intracellular hyaline body.
Ischemia-Reperfusion syndrome is characterized by:
Which of the following are metabolic causes of splenic enlargement?
Cell Injury and Cell Death
Practice Questions
Adaptations of Cellular Growth
Practice Questions
Accumulations and Deposits
Practice Questions
Acute and Chronic Inflammation
Practice Questions
Tissue Repair and Wound Healing
Practice Questions
Hemodynamic Disorders
Practice Questions
Genetic Disorders
Practice Questions
Environmental Pathology
Practice Questions
Nutritional Diseases
Practice Questions
Molecular Basis of Disease
Practice Questions
Get full access to all questions, explanations, and performance tracking.
Scan to download app